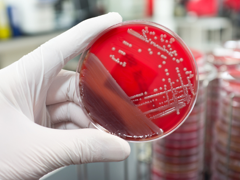
Düfte gegen Staphylokokken und Bakterien

Geruchssituation
Mit jedem unserer Atemzüge erreichen Duftstoffe unser Riechsystem. Die Verknüpfung von Riechen und Erinnern ermöglicht uns, Assoziationen von erinnerten Szenen und aktuellen Geruchsempfindungen zu erleben. Duft kann so zum Wohlbefinden oder zum Unwohlsein führen.

Kontakt
Kontakt Preisliste
Preisliste